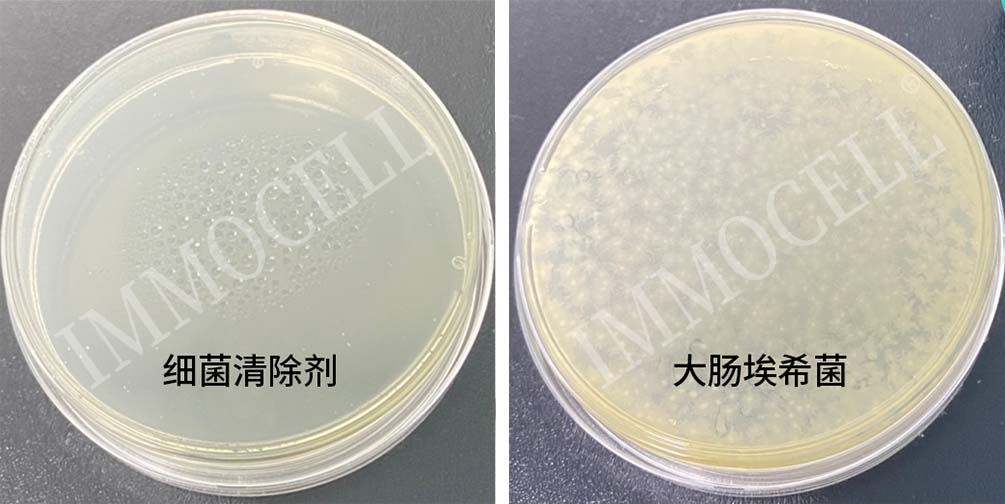
细菌清除剂(1000X)试用装

相关产品推荐更多 >
万千商家帮你免费找货
0 人在求购买到急需产品
- 详细信息
- 技术资料
- 供应商:
厦门逸漠生物科技有限公司
- 规格:
200ul
CellShieldTM 细菌清除剂产品简介
当细胞出现细菌污染,会在显微镜下看到一些游动的小虫子,对青霉素、链霉素等各种抗 生素都有很强的耐药性,且增殖速度快。CellShieldTM 细菌清除剂其主要成分为抗菌复合物,适 用于细胞培养过程中细菌污染的清除,仅 12 小时就可以显著抑制细菌生长,一周左右即可清 除细菌污染,一定程度上挽救珍贵的细胞,减少细菌污染带来的损失。
CellShieldTM 细菌清除剂使用说明
从-20℃冰箱内取出细菌清除剂,将试剂管瞬时离心(3000rpm ,3~5s)后放置于 EP 管架上, 用 75%的酒精喷洒试剂管的表面,在生物安全柜中进行无菌操作;
以 T25 细胞培养瓶为例
对于已检测或怀疑有细菌污染的细胞,在细胞培养基中加入适量细菌清除剂,通常推荐使 用的稀释倍数为 1000x ,如:6 mL 的细胞培养基加入 6 μL 的细菌清除剂混匀。连续加药培养 1-2 周即可有效清除细菌污染。
贴壁细胞换液或传代前,弃去旧的培养基,用含 1000x 细菌清除剂的 PBS 轻轻冲洗细胞 表面 2 次。悬浮细胞、贴壁不牢的细胞、半贴半悬细胞换液或传代前,可利用细菌直径远小于 细胞直径的特点,采用 150 g(或 500rpm)低速离心 5min ,弃去旧的培养基,再用含 1000x 细菌 清除剂的 PBS 轻轻冲洗细胞 2 次。
用含药 PBS 清洗细胞后,加入含有细菌清除试剂的新鲜完全培养基(传代后铺细胞需更换 为新的瓶/板) ,1 天换液 1 次,连续加药 l~2 周(或传代 3 次) ,若细菌污染非常严重时,需增加 换液频率和延长处理时间。
CellShieldTM 细菌清除剂产品效果
1. 未加药的细胞在第二天全部死亡,细菌增殖多,且细胞培养基明显变黄;加药的细胞第二 天细菌生长明显受抑制,细胞正常生长,加药 5 天后细菌基本清楚干净。

2. 平板抑菌实验中,加入 CellShieldTM 细菌清除剂的平板无菌生长。
注意事项
1.为了发挥药效,含药培养基建议现配现用,如果加药培养基未用完,于 4℃ 冰箱中 避光保存,2 周内用完,使用培养基前需预热至 37℃。
2.如遇个别细胞对本试剂敏感,细胞生长速度明显受影响时,建议减量使用或进行稀释度测试。
3.细菌清除剂处理后,会有很好的预防和清除效果,但是如果环境或使用试剂中仍有污染源存 在,细胞可能会再次污染,因此需做好适当的预防措施。
4.加入本产品进行细菌预防和清除时,无需添加双抗(青霉素-链霉素)。
5.本产品仅限于专业人员的科学研究用,不得用于临床诊断或治疗,不得用于食品或药品,不 得存放于普通住宅内。
6.为了您的安全和健康,请穿实验服并戴一次性手套操作。
风险提示:丁香通仅作为第三方平台,为商家信息发布提供平台空间。用户咨询产品时请注意保护个人信息及财产安全,合理判断,谨慎选购商品,商家和用户对交易行为负责。对于医疗器械类产品,请先查证核实企业经营资质和医疗器械产品注册证情况。











